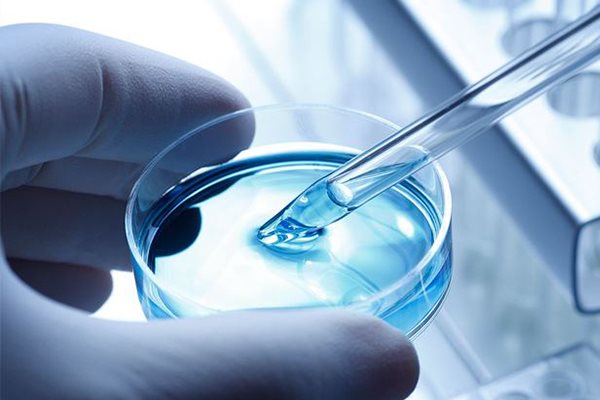

Expertenwissen für gesunde Haut
Finde heraus, was deine Haut braucht und entdecke individuelle Pflegeempfehlungen für deinen Hauttyp und deine Bedürfnisse.
Artikel filtern
Körperregion
Hautzustand